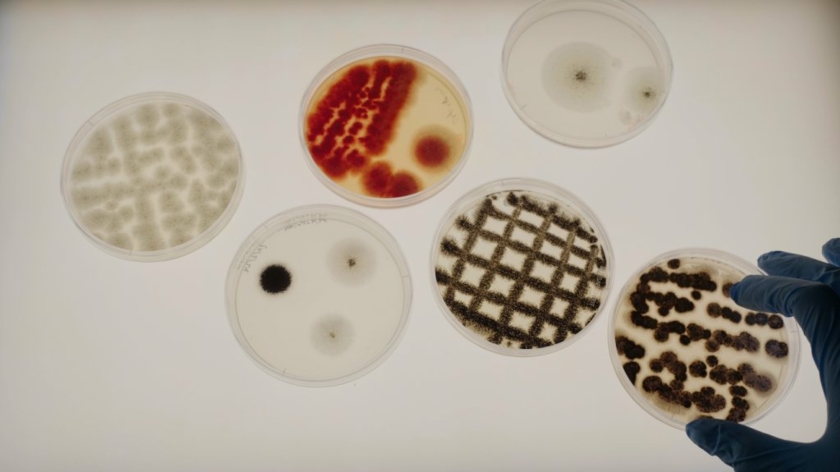

18.06.25 – Projekt FunColor
Biobasierte Textilfarben aus Pilzen
Das Projekt FunColor erforscht die Herstellung von Melanin-Farbstoffen auf Pilzbasis als biologischer Ersatz für chemisch-synthetisierte grau-braun-schwarze Textilfarben.
Ziel von FunColor ist es, ein biotechnologisches Verfahren zur Herstellung von biologischen Farbpigmenten zu entwickeln. © ITA

